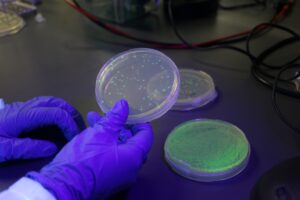

Crearon un test para detectar glifosato en alimentos y bebidas
Investigadores de la UNSE elaboraron un test para detectar glifosatos en alimentos y bebidas. El proyecto a cargo de Javier González, doctor en Ciencias Biológicas se desarrolla en el Instituto de Bionanotecnología del NOA (Inbionatec), de doble dependencia UNSE-CONICET.
El glifosato es un herbicida que se utiliza para matar malezas y pastos que compiten con los cultivos. “No se degrada tan rápido en el tiempo. Es más, al regar una planta con flores, el glifosato permanece en el néctar, que luego lo llevan las abejas y producen miel contaminada por glifosato. Por eso es importante saber dónde está”. se refirió el Dr. González sobre el funcionamiento del glifosato.
Este proyecto hace foco en una enzima que permitió crear tiras reactivas (test colorimétrico) que cambian de color ante la presencia o detección del glifosato en cualquier prueba que contenga agua (alimento, miel, jugos de frutas, vinos, suelos, etc.)
A nivel mundial, ya hay ensayos de este tipo, pero con este proyecto se reduce el costo de importar los insumos para medir el glifosato, ya que, si un test es caro, poca gente lo va a utilizar y habrá poco control del uso de este herbicida.
Los usuarios de este test, serán los Ing. Agrónomos, los productores agrícolas que usan glifosato a diario, pero en principio el punto general, que podrá controlar el agua, la miel, el jugo que consumen, etc.
Actualmente, el equipo de trabajo busca determinar qué cantidad mínima de glifosato se necesita para que la enzima la detecte y el test cambie de color. Hoy el proyecto se encuentra a un 70% del avance. La idea se enmarca en un proyecto mas amplio, cuyo campo de estudio son las Salinas de Ambargasta.
El equipo que forma parte de este proyecto de investigación está conformado por: Javier González (Dr. en Cs. Biológicas y Dir. del proyecto); María Belén López (Lic. en biotecnología y doctorada en Cs. Biológicas); Andrea Zerda Moreira (Lic. en genética y doctorada en Cs. Biológicas) y Constanza Barrionuevo Reyes (estudiante de Lic. en biotecnología).